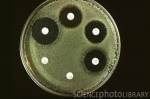
Đĩa Kháng Sinh - Kháng Nấm
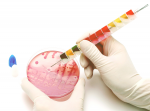
Dụng Cụ Test Nhanh Sinh Hóa Vi Sinh

Thông tin công ty
Công Ty TNHH TMDV Hữu Thường

- Lượt xem: 1956
- Địa chỉ:
- Điện thoại: 0917868726
- Fax:
- Email: ainhuvuonglam@gmail.com
- Sky:

-
Đĩa Kháng Sinh - Kháng Nấm
[Mã: G-17665-2] [xem: 3204]
[Nhãn hiệu: Liofilchem - Xuất xứ: Italia]
[Nơi bán: ]
2012-09-06 10:03:47] Mua hàngCông Ty TNHH TMDV Hữu Thường
ainhuvuonglam@gmail.com -
Dụng Cụ Test Nhanh Sinh Hóa Vi Sinh
[Mã: G-17665-3] [xem: 1637]
[Nhãn hiệu: Liofilchem - Xuất xứ: Italia]
[Nơi bán: ]
2012-09-06 10:12:46] Mua hàngCông Ty TNHH TMDV Hữu Thường
ainhuvuonglam@gmail.com -
Môi Trường Kiểm Tra Vi Sinh
[Mã: G-17665-1] [xem: 1512]
[Nhãn hiệu: Liofilchem - Xuất xứ: Italia]
[Nơi bán: ]
2012-09-06 09:59:56] Mua hàngCông Ty TNHH TMDV Hữu Thường
ainhuvuonglam@gmail.com -
Test Nhanh Vi Sinh Trong Thực Phẩm ( Food System)
[Mã: G-17665-6] [xem: 1472]
[Nhãn hiệu: LIOFILCHEM - Xuất xứ: ITALIA]
[Nơi bán: ]
2012-09-25 04:06:28] Mua hàngCông Ty TNHH TMDV Hữu Thường
ainhuvuonglam@gmail.com -
Kit kiểm tra nhanh nội độc tố Aflatoxin trong thực phẩm-dược phẩm
[Mã: G-17665-4] [xem: 1412]
[Nhãn hiệu: ARTRON - Xuất xứ: CANADA]
[Nơi bán: ]
2012-09-25 03:52:33] Mua hàngCông Ty TNHH TMDV Hữu Thường
ainhuvuonglam@gmail.com -
Test vệ sinh bề mặt-contact slide
[Mã: G-17665-5] [xem: 1364]
[Nhãn hiệu: LIOFILCHEM - Xuất xứ: ITALIA]
[Nơi bán: ]
2012-09-25 03:58:39] Mua hàngCông Ty TNHH TMDV Hữu Thường
ainhuvuonglam@gmail.com
Chọn sản phẩm để
Công ty TNHH TMDV
Sinh Việt hiện đang là nhà phân phối các mặt hàng kit xét nghiệm, thiết bị, dụng cụ dùng trong kiểm nghiệm, chẩn đoán bệnh phẩm, thực phẩm, nước, môi trường….theo tiêu chuẩn quốc tế như: ISO, AOAC, AFNOR, APHA, European Pharmacopoeia (EP), United States Pharmacopoeia (USP), CLSI,….
Luôn cam kết hợp tác với Quý khách hàng trên tiêu chí:
- Cung cấp sản phẩm với giá hợp lý, ổn định, chất lượng.
- Hỗ trợ tư vấn kỹ thuật khi khách hàng có nhu cầu.
- Hỗ trợ đào tạo nhân viên kĩ thuật trực tiếp sử dụng sản phẩm.
Hãy để chúng tôi chia sẽ những khó khăn của Quý khách hàng trên con đường phát triển trong nền kinh tế hội nhập toàn cầu